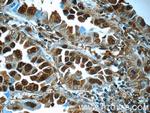
PSMA6 Antibody in Immunohistochemistry (Paraffin) (IHC (P))

Search
Proteintech
PSMA6 Polyclonal Antibody
{{$productOrderCtrl.translations['antibody.pdp.commerceCard.promotion.promotions']}}
{{$productOrderCtrl.translations['antibody.pdp.commerceCard.promotion.viewpromo']}}
{{$productOrderCtrl.translations['antibody.pdp.commerceCard.promotion.promocode']}}: {{promo.promoCode}} {{promo.promoTitle}} {{promo.promoDescription}}. {{$productOrderCtrl.translations['antibody.pdp.commerceCard.promotion.learnmore']}}

Please note: We are reviewing Western blot images included in the antibody testing data in our catalog, including those provided by third parties. Unless expressly labeled or annotated as “raw-unedited”, Western blot images included in the antibody testing data in our catalog may have been edited, optimized or otherwise adjusted for presentation.
Product Details
11573-1-AP
Species Reactivity
Published species
Host/Isotype
Class
Type
Immunogen
Conjugate
Form
Concentration
Amount
Purification
Storage buffer
Contains
Storage conditions
Shipping conditions
Product Specific Information
Immunogen sequence: MSRGSSAGF DRHITIFSPE GRLYQVEYAF KAINQGGLTS VAVRGKDCAV IVTQKKVPDK LLDSSTVTHL FKITENIGCV MTGMTADSRS QVQRARYEAA NWKYKYGYEI PVDMLCKRIA DISQVYTQNA EMRPLGCCMI LIGIDEEQGP QVYKCDPAGY YCGFKATAAG VKQTESTSFL EKKVKKKFDW TFEQTVETAI TCLSTVLSID FKPSEIEVGV VTVENPKFRI LTEAEIDAHL VALAERD (1-246 aa encoded by BC023659)
Target Information
The proteasome is a multicatalytic proteinase complex with a highly ordered ring-shaped 20S core structure. The core structure is composed of 4 rings of 28 non-identical subunits; 2 rings are composed of 7 alpha subunits and 2 rings are composed of 7 beta subunits. Proteasomes are distributed throughout eukaryotic cells at a high concentration and cleave peptides in an ATP/ubiquitin-dependent process in a non-lysosomal pathway. An essential function of a modified proteasome, the immunoproteasome, is the processing of class I MHC peptides. This gene encodes a member of the peptidase T1A family, that is a 20S core alpha subunit. A pseudogene has been identified on the Y chromosome.
For Research Use Only. Not for use in diagnostic procedures. Not for resale without express authorization.
Bioinformatics
Protein Aliases: alpha-1; Macropain iota chain; MGC22756; MGC2333; MGC23846; Multicatalytic endopeptidase complex iota chain; PROS 27; proteasome alpha 6 subunit; Proteasome iota chain; Proteasome subunit alpha type-6; Proteasome subunit alpha-1; PSA6; PSMA 6
Gene Aliases: IOTA; Psma6
UniProt ID: (Mouse) Q9QUM9, (Rat) P60901
Entrez Gene ID: (Mouse) 26443, (Rat) 29673

Performance Guarantee
If an Invitrogen™ antibody doesn't perform as described on our website or datasheet,we'll replace the product at no cost to you, or provide you with a credit for a future purchase.*
Learn more
We're here to help
Get expert recommendations for common problems or connect directly with an on staff expert for technical assistance related to applications, equipment and general product use.
Contact tech support

